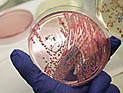
Ученые: кошерная курятина содержит вдвое больше кишечной палочки, чем обычная

Здоровье
adv_09 rimma_dw_d
adv_10 rimma_dw_m
adv_11 ca_instrip_direct
Из-за сопротивления родителей и раввинов, в некоторых религиозных школах не будет проходить вакцинация от папилломавируса
Минздрав согласился не проводить в части религиозных школ вакцинацию от рака шейки матки, от которого ежегодно умирают в Израиле около сотни женщин, в связи с сопротивлением родителей и раввинов.
adv_12 ca_instrip_direct
Здоровье ::
9 Ноября 2013 г.